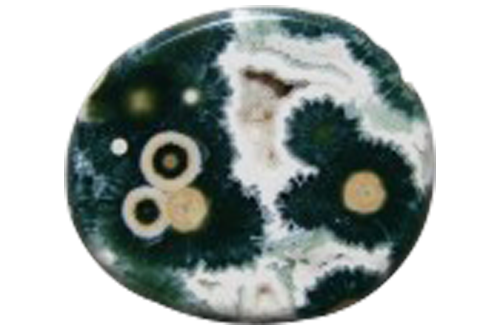
Magnifique pierre de jaspe

Le Jaspage
Chaque livre a son aspect unique, mais la façon la plus sûre de lui donner une apparence hors du commun est de rendre sa tranche différente de celles des autres livres – soit par une colorisation, soit par une dorure, soit par un dessin. Pour effectuer ceci, la finition de votre livre doit se terminer par un jaspage.
Dans les lignes qui suivent nous allons voir ce que représente le jaspage, d’où il vient, quel est son état actuel et surtout – comment Pulsio Print peut vous aider à embellir vos livres en appliquant le jaspage.
Qu’est-ce que le jaspage ?
Aujourd’hui on appelle « jaspage » toutes les activités liées à l’embellissement de la tranche d’un livre.
Selon l’Encyclopédie méthodique, paru vers la fin de 18e siècle:
Les embellissements de la tranche consistent à y mettre une couleur rouge, ou une jaspure, ou une marbrure, souvent une dorure ; quelquefois même on y fait de petits dessins de figures arbitraires ou singulières, ce qu’on appelle « antiquer sur tranche ».
Dans le livre L’Art Et la Pratique en Reliure, paru en 1898 e(et dont la dernière réimpression date de 2016 !) on parle de l’ORNEMENTATION DES TRANCHES :
Faire la tranche – C’est ainsi que l’on dénomme les opérations par lesquelles on couvre la tranche d’un volume d’une couleur soit unie, soit jaspée ou marbrée ou encore d’une couche d’or ou d’argent.

Anciennes tranches marbrées
Les origines du nom “Jaspage”
Le mot « jaspage » signifie travail qui consiste à faire des jaspures, c’est-à-dire des imitations de jaspe sur une boiserie, sur un mur, sur une pièce en métal, sur la tranche d’un livre, etc. Le Tome 4 d’un autre ouvrage important – Connaissances Nécessaires à Un Bibliophile, nous fait découvrir qu’à la fin du 17e siècle, et pendant tout le 18e on utilisait le jaspage sur le fauve du cuir, destiné à la reliure.
Le jaspe est une roche sédimentaire qui peut avoir plusieurs aspects : tacheté, rubané, rouge (ou oriental), à taches rouges sur fond vert, noir (de Sicile), etc.
D’origine sédimentaire ou volcanique, c’est donc un minéral de transformation, parfois classifié comme minéral, parfois comme roche, selon le point de vue ou son taux d’impuretés. Sa particularité essentielle, outre son abondance, est sa large palette de coloris naturels.
On peut estimer, a priori, qu’aucun coloris n’est impossible pour le jaspe, ce qui permet de donner son nom à toutes les surfaces portant une colorisation variée.

Différentes variétés du jaspe
Application ancienne du jaspage
Le Tome VIII des Descriptions des arts et métiers, sorti en 1777 dans sa partie ART DU RELIEUR, donne des techniques d’application de tous les modes d’embellissement de la tranche.
L’Encyclopédie méthodique nous apprend que « nos anciens livres du seizième siècle […] presque tous, sont antiqués sur tranche ». On antique sur la tranche « si l’on veut encore pousser la recherche et la magnificence plus loin ».
L’esthétique de l’époque imposait l’ornementation des tranches en tant que partie intégrale de l’aspect d’un livre. Son importance est telle que selon L’Art Et la Pratique en Reliure :
Ce sont généralement des ouvriers spéciaux qui jaspent, marbrent ou dorent, mais il est utile que le relieur connaisse tout au moins les procédés que l’on emploie, il pourra, si besoin est, se passer de l’aide des spécialistes, surtout s’il habite une petite ville.
Et si l’Encyclopédie méthodique parle de la couleur rouge à mettre sur la tranche, une centaine d’années plus tard L’Art Et la Pratique en Reliure décrit toutes les couleurs et nous donne minutieusement des recettes pour préparer les encres pour colorer la tranche uniformément ou avec jaspage.
La demande et de là – les techniques se développent. Le jaspage devient presque une tendance de mode avec ses modèles réservés par les grandes imprimeries de l’époque. L’Art Et la Pratique en Reliure nous donne des idées sur quelques modèles d’une certaine maison A. Scherf, 19, rue Saint-Séverin, Paris.



Mais faire la tranche (notre jaspage d’aujourd’hui) ne sert pas seulement pour l’embellir. L’utilité pratique de ce procédé n’est pas à négliger. Selon les propos de l’auteur de l’article sur lui dans l’Encyclopédie, déjà citée :
Quoique ces couleurs et ornements ne paraissent que de simple agrément et qu’il semble qu’ils n’ajoutent aucun mérite ni avantage réel au livre, je ne les crois pas tout à fait inutiles, soit pour empêcher les feuilles de s’user si promptement, soit pour empêcher les taches d’y paraître aussi visiblement que si la tranche restait dans la couleur du papier; du moins me paraît si sûr que certains livres d’usage, tels, par exemple, que ceux que nous portons aux églises se conservent plus longtemps propres quand ils sont dorés sur la tranche, que quand ils sont simplement rougis ou jaspés, comme cela se pratique pour les livres que les libraires vendent tout reliés.
Donc, en ces temps où les tirages étaient réduits et les livres passaient de main en main, le jaspage servait aussi à assurer leur protection.
Le jaspage de nos jours
Aujourd’hui le jaspage a perdu son rôle de protecteur. Mais le temps a fait en sorte que, contrairement à ce que disait l’Encyclopédie méthodique, il ajoute justement des avantages réels à un livre. Le livre avec jaspage se distingue de loin. Il attire les regards. C’est d’abord la particularité du jaspage qui nous accroche, mais ensuite dans notre esprit vient la réflexion que l’imprimeur a fait quelque chose de plus pour ce livre (à part l’impression et la reliure) et cet effort mérite au moins notre attention.
Nous ne sommes plus à l’époque de L’Art Et la Pratique en Reliure – la plupart des procédés dans l’impression et la reliure sont industrialisés. Le jaspage en fait partie et ceci permet parfois de jasper des tirages importants. Mais le travail de qualité, qui impressionne le plus et qui ajoute une valeur maximale au livre se fait toujours à la main.
Souvent les films (ou ‘foils’) pour les jaspages métallisés (dorures de la tranche ou autres) proviennent de mêmes fournisseurs que les films, destinés au marquage à chaud. Le leader mondial du marché est sans doute la société allemande Kurtz. Pour colorer la tranche, on utilise des aérosols ou des tampons spéciaux.
Pulsio Print et le jaspage
Forte de sa longue expérience, Pulsio Print est capable de réaliser toutes vos idées d’embellissement des tranches de vos livres.
Leur conférer une classe à part avec de l’or ou une couleur unie :




Leur apporter plus du style avec une réplique d’une couleur de la couverture sur la tranche :


Ou bien créer une tranche amusante avec des couleurs vives, correspondantes au contenu du livre :


Si vous avez d’autres proposition et souhaits de jaspage, d’autres modèles ou création artistiques, n’hésitez pas à nous contacter. Ensemble, nous allons les étudier et les réaliser, pour que vos livres deviennent remarquables et uniques.
Calculez vos économies d’impression maintenant!